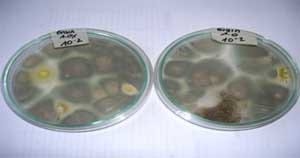
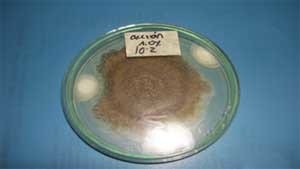

Se verificó el efecto inhibitorio de tres productos Comerciales, cuyo principio activo es el ácido propiónico y el propianato de amonio, sobre los mohos presentes en el maíz amarillo, mediante un ensayo de Laboratorio simulando las condiciones de almacenamiento del grano. Se probaron 4 dosis según las recomendaciones del fabricante (0.05, 0.10, 0.15 y 0.20 Kg/Ton) y la humedad del maíz se mantuvo entre 9.3 y 11.6%. El tratamiento se aplicó durante 7 semanas a una Temperatura de 25°C. Se realizó recuento de mohos empleando agar Saboreaud a un pH 5.0 y finalmente se identificaron los mohos presentes en el Maíz. Los resultados mostraron que los tres Antifúngicos Fungitek Dry, Action y Grain fueron efectivos en la reducción del crecimiento de mohos de tal forma que partiendo de una carga inicial de 38500 ufc/g fueron reducidos a niveles tan bajos como 100 ufc/g. Ciertos mohos mostraron mas resistencia que otros, como Penicillium sp. y Aspergillus sp. Los autores sugieren que los productos Antifúngicos se apliquen antes de que proliferen los mohos en los silos de almacenamiento y que se controlen otras variables como la humedad, la temperatura y las plagas para que el empleo de los mismos de la certeza y la seguridad de que se eliminaron los mohos naturales presentes en el Maíz.
INTRODUCCION
El maíz amarillo, importante cereal cultivado en Colombia y Venezuela, ocupa la segunda extensión más grande de tierra cultivada. En Colombia 359 mil hectáreas según cifra del DANE 2004 con una producción de 1.2 millones de Ton (6). Y Venezuela con 159 mil hectáreas cultivadas y 457 mil toneladas de producción según FEDEAGRO 2005 (8) (11). Sin embargo, esta cantidad no abastece la demanda de Maíz para el consumo interno de industrias como la de Alimentos Balanceados de Animales e industrias de producción de harinas de Maíz. (8)
Una de las limitantes para la producción de maíz actualmente son los problemas fitosanitarios, la sanidad, manchas de asfalto y por su puesto la invasión de hongos, con la subsecuente producción de micotoxinas.(4), la FAO (1991) las define como metabolitos de hongos que provocan cambios patológicos tanto en seres humanos como animales, y la micotoxicosis, es los síndromes de la toxicidad resultante de la absorción de micotoxinas. (7)
Es muy común encontrar granos contaminados, por ejemplo Yiannikouris y Jouany (2002) señalan que a nivel mundial alrededor del 25 % a 40% de los alimentos cosechados anualmente son afectados por micotoxinas.(15) La presencia de micotoxinas es común en todos los alimentos de uso animal, Un estudio realizado por la Universidad Carolina del Norte de los EEUU en el 2002 mostró las siguientes cifras en granos de maíz: 70% de muestras positivas para Deoxynivalenol, 37% para fumonisinas, 11% para zearalenona, 9% para aflatoxinas, y 6 % para Toxin T2, de un total de 231 muestras analizadas. (14)
De otro lado, los mohos por ser organismos vivos utilizan los alimentos como sustrato para su desarrollo, al hacerlo disminuyen la composición nutricional (vitaminas, carbohidratos, proteínas, aminoácidos entre otros) (1), esto produce una importante pérdida de palatabilidad, al tiempo que ocasiona disminución del peso en los animales de consumo.
La manera más efectiva para evitar los problemas ocasionados por las micotoxinas es impedir que el hongo crezca en el sustrato. En el caso de granos almacenados, esto se puede lograr de varias formas, como: 1) Mantener la humedad del grano por debajo de los requerimientos de agua del hongo; 2) Conservar los granos a temperaturas inferiores a 10°C, con el riesgo de que se desarrollen hongos que pueden crecer a esas temperaturas, como Penicillum, además puede resultar costoso pues se requeriría de condiciones de refrigeración sobre todo cuando se manejan grandes volúmenes de granos para la alimentación humana y animal; 3) Evitar la germinación de las esporas de los hongos, así como el desarrollo del micelio en el sustrato susceptible de ser contaminado con estas micotoxinas, mediante el uso de inhibidores químicos (10).
Al respecto, el uso de sustancias químicas, en particular de ácidos orgánicos y sus sales (Sauer y Burroughs, 1974), para prevenir la producción de micotoxinas es una alternativa con grandes posibilidades de uso. (12). Las primeras formulaciones de ácido propiónico que salieron al mercado se emplearon para el tratamiento de granos de maíz con alto contenido de humedad (entre 20 y 30 %) destinados a la alimentación directa del ganado vacuno (Sauer y Burroughs, 1974), sin embargo el uso de este ácido presenta la desventaja de ser muy corrosivo y volátil. (12)
Recientemente han salido al mercado otras formas de presentación de productos derivados del ácido propiónico para proteger de la contaminación por mohos a los granos almacenados y a los alimentos balanceados. Por ejemplo, el ácido propiónico amortiguado mediante procesos especiales produce la formación de un complejo (dipropionato de amonio, es decir, dos iones de propionato y un ión de amonio) que provee mayor capacidad “Bufferada” que un sistema convencional sal-ácido. Este complejo amortiguado se disocia en presencia de la humedad contenida en el alimento o en los granos, esto libera propionato libre y prevé un máximo de inhibición de hongos. (9)
Bajos los preceptos mencionados se deriva la importancia de contar con inhibidores efectivos que eviten, durante el almacenamiento de los granos y la vida de anaquel de los alimentos balanceados, el desarrollo de los hongos productores de micotoxinas y que a su vez dichos inhibidores no sean corrosivos, no causen daño en la piel a los operadores, y que tengan una baja volatilidad.
En consecuencia, los industriales deben preocuparse por conocer e investigar con exactitud los productos inhibidores fúngicos idóneos y la dosis óptima que contribuyan con certeza en evitar la proliferación de dichos microorganismos.
Por esta razón el propósito del presente trabajo fue analizar el efecto inhibidor de tres productos comerciales a base de sales derivados del ácido propiónico “FUNGITEK DRY, ACTION Y GRAIN” en sus presentaciones liquidas y sólidas, evaluando así el cumplimiento normativo para la inhibición del crecimiento de mohos que en consecuencia servirán como alternativa en el control del desarrollo de las micotoxinas en el maíz almacenado.
MATERIALES Y MÉTODOS
Selección de la muestra de Maíz
Se analizaron varias muestra de Maíz amarillo que cumplieran con las características de almacenamiento de materias primas empleados por los productores de alimentos concentrados y se tuvo en cuenta que la muestra seleccionada contara con una carga representativa de Mohos para su estudio, para ello se seleccionaron tres tipos de presentación de Maíz evaluándose sus características microbiológicas y el grado de humedad. Las muestras evaluadas fueron: Maíz Entero (1 Kg.), Maíz partido (1 Kg.) y Maíz molido (1 Kg).
Antifúngicos experimentales
Los inhibidores de mohos empleados para el ensayo fueron tres productos comerciales que contienen acido propiónico y propianato de amonio como compuestos activos. En sus presentaciones sólidas y líquidas. En la tabla 1 se detalla su composición y su presentación.
Tabla 1. Productos antifúngicos
ANTIFUNGICO | Composición | Presentación |
FUNGITEK DRY | Propianato de amonio | Sólido |
FUNGITEK ACTION | Propianato de Amonio | Líquido |
FUNGITEK GRAIN | Propianato de amonio | Líquido |
Fuente: Ficha Técnica suministrada por ZOOTEK C.A Venezuela
Unidades experimentales
Una vez seleccionada la muestra de Maíz (Maíz amarillo partido) de manera aleatoria, se pesaron las muestras y se depositaron (1 Kg. para cada prueba) en frascos de vidrio previamente esterilizados y tapados, con orificios que permiten eliminar el dióxido de carbono originado por la respiración del grano y de los mohos. Se realizaron 12 pruebas con 4 concentraciones diferentes y una sola repetición el arreglo factorial fue de: 1x3x4 y un frasco control. La dosificación se realizó según la recomendación comercial. La distribución fue la siguiente:
Tabla 2. Dosificación de los productos antifúngicos.
Producto | Número de Pruebas | Dosis comerciales | Concentración |
FUNGITEK DRY | 4 | 0,5 Kg./Ton | 0,05% |
FUNGITEK ACCION | 4 | 0,5 L/Ton | 0,05% |
FUNGITEK GRAIN | 4 | 0,5 L/Ton | 0,05% |
CONTROL | 1 | 0,0 Kg/Ton | 0,00% |
El tiempo del ensayo fue de 7 semanas, con muestreos semanales. La temperatura de incubación fue de 25°C temperatura óptima para el crecimiento y desarrollo de los mohos y la humedad del Maíz inicial de 10,3%.
Los Análisis de laboratorio fueron: Humedad, temperatura, recuento de mohos e identificación.
Las pruebas de humedad se realizaron por el método de Pérdida de peso por desecación a 105 ºC en una balanza de secado.
Cuantificación de mohos presentes en el Maíz
Para analizar el efecto de los antifúngicos se cuantificaron los mohos, empezando por el frasco control y continuando por cada uno de las pruebas. Observándose si se presentaba disminución, aumento o un número estable de los mohos, frente a las diferentes concentraciones y al tiempo de exposición.
El procedimiento aplicado fue el propuesto por las Normas Covenin Venezolanas (5), se empleó la técnica de placa profunda para mohos y levaduras, se uso el agar saboreaud ajustando el pH a 5.0 (para inhibir la presencia de bacterias.) La temperatura de incubación fue de 25 °C y el tiempo de 3 días. Los análisis se realizaron por duplicado en tres diluciones y/o cuatro diluciones según el caso.
Identificación de Mohos
En cada ensayo se observaron macroscópicamente las características de las colonias de los mohos y microscópicamente las estructuras, hifas, micelio, esporos etc., identificando así el género correspondiente.
RESULTADOS Y DISCUSIONES
Selección de la muestra de maíz
Tabla 3. Prueba de selección del maíz.
| Muestras | Maíz entero | Maíz partido | Maíz Molido |
1 | 21.000 ufc/g | 38.500 ufc/g | 150.000 ufc/g |
2 | 17.500 ufc/g | 35.000 ufc/g | 162.000 ufc/g |
Se seleccionó el maíz partido porque presentaba un número de mohos representativos para el estudio y por su facilidad de manejo en las pruebas de Laboratorio. Ver Tabla 3
En la Tabla 4 se observa el efecto inhibitorio por parte de los componentes activos de los tres Antifúngicos y se denota que al aumentar la dosis, disminuye de manera proporcional el recuento de mohos. La curva de inhibición de mohos observada para el FUNGITEK GRAIN en la Figura 1, muestra una correlación de 0,698 en la concentración 0,05% demostrando así que hay un descenso progresivo semana por semana durante todo el ensayo.
Los recuentos durante las siete semanas a una temperatura promedio de 25°C se ajustan a los valores permitidos según la NTC 3749 (cereales en hojuelas), el cual indica que el rango permisible de mohos debe estar en 5000 ufc/g. (m) y 10000 ufc/g. (M). Para el grano de Maíz la normativa NTC 366 no contempla valores microbiológicos, pero debe cumplirse el aspecto sanitario sobre libre de infestaciones. (13)
El control por su parte aumentó de 38.500 ufc/g. a 150.000 ufc/g. en tan solo tres semanas, indicando que con el transcurrir del tiempo los mohos se van multiplicando de forma logarítmica.
Comparativamente entre los tres productos comerciales no se observó una diferencia significativa, puesto que presentan una actividad inhibitoria similar lográndose obtener valores mínimos de 300 ufc/g con el FUNGITEK GRAIN, 200 ufc/g con el FUNGITEK DRY y 100 ufc/g con el FUNGITEK ACTION, a una temperatura de 25° C y a una humedad entre 9,3% y 11,6%. Siendo estos valores permitidos según el Codex Alimentarius (2)
Tabla 4. Recuento de Mohos durante 6 y 7 semanas de tratamiento
CONCENTRACIÓN | ||||||||
FUNGITEK DRY | ||||||||
S0 | S1 | S2 | S3 | S4 | S5 | S6 | S7 | |
0,00% | 38500 | 150000 | 141000 | 150000 | ||||
0,05% | 18000 | 24000 | 21000 | 6800 | 2600 | 6500 | 5700 | |
0,10% | 19600 | 16000 | 15000 | 2450 | 300 | 6000 | 4800 | |
0,15% | 16000 | 8000 | 2000 | 3900 | 300 | 5800 | 2000 | |
0,20% | 16000 | 4000 | 300 | 7300 | 200 | 1000 | 1200 | |
FUNGITEK ACTION | ||||||||
S0 | S1 | S2 | S3 | S4 | S5 | S6 | ||
0,00% | 38500 | 150000 | 141000 | 150000 | ||||
0,05% | 33000 | 3600 | 2300 | 5000 | 3300 | 2900 | ||
0,10% | 5000 | 550 | 2300 | 7000 | 3300 | 3900 | ||
0,15% | 2000 | 100 | 1100 | 8000 | 1700 | 800 | ||
0,20% | 3000 | 650 | 5500 | 7000 | 1600 | 1000 | ||
FUNGITEK GRAIN | ||||||||
S0 | S1 | S2 | S3 | S4 | S5 | S6 | ||
0,00% | 38500 | 150000 | 141000 | 150000 | ||||
0,05% | 9100 | 3800 | 3450 | 2600 | 1600 | 2000 | ||
0,10% | 9200 | 2800 | 1000 | 800 | 1300 | 1800 | ||
0,15% | 850 | 1500 | 2050 | 300 | 500 | 500 | ||
0,20% | 400 | 400 | 400 | 1900 | 1000 | 1200 |
Las dosis mínimas óptimas que disminuyeron la proliferación de los mohos fueron de 0,1 Kg/L para el FUNGITEK DRY y de 0,5 Kg/L para los FUNGITEK ACTION y GRAIN.
El contenido de humedad del maíz, elemento importante de su composición química, es uno de los factores que contribuye al deterioro biológico del maíz y a la proliferación de mohos. El maíz con humedad elevada, de textura blanda, se deteriora con facilidad durante el almacenamiento, mientras que el cereal con niveles bajos de humedad se quiebra. El nivel de humedad más aceptado para la comercialización del maíz es 15.5% (2).
Los resultados obtenidos permiten corroborar que el maíz mantuvo una humedad que se encontraba dentro de los valores permisibles durante el tiempo del ensayo. Ver Tabla 5
Figura 1. Curva de inhibición de mohos frente a las Concentración 0,05%, 0,10%, 0,15% y 0,20% FUNGITEK GRAIN
Tabla 5. Pruebas de humedad.
| Ensayos | Maíz sin Producto | Maíz Fung | Maíz Fung | Maíz Fung |
T. almacenamiento | Sem 0 | Sem 2 | Sem 4 | Sem 6 |
10.3 % | 11.6 % | 9.3 % | 10.8 % |
Los mohos predominantes en el Maíz del ensayo fueron: Aspergillus sp, Penicillum sp,Rhizopus sp y Fusarium sp., de estos, los más resistentes: Aspergillus sp y Penicillum sp. Existe la posibilidad de que dichos mohos aporten micotoxinas como Aflotoxinas B1, B2, G1 y G2 producidas por Aspergillus sp y/o Ocratoxina A producida por Penicillum sp.
En las fotos (Figura 2 y 3) se pueden apreciar algunos de los mohos observados, y en la Figura 4 se muestra los porcentajes de los mohos identificados durante todo el ensayo. 

Figura 4. Porcentaje de Mohos identificados
Figura 2 y 3. Crecimiento del hongo Penicillum sp. aislado del maiz
Aspergillus sp. aislado del Maíz
Fuente: Fotografía tomada en el laboratorio de Microbiología, Universidad de Santander, Cucuta, 2007.
| CONCLUSIONES Los productos inhibidores de mohos de nombres comerciales FUNGITEK DRY, ACTION Y GRAIN que contienen como principio activo ácido propiónico y propionato de amonio en todas sus dosis comerciales 0.5, 1.0, 1.5, 2.0 Kg/L mostraron ser efectivos en la reducción del crecimiento de mohos presentes en el maíz y por tanto de sus micotoxinas durante 7 semanas de almacenamiento en condiciones controladas. Desde la primera semana del ensayo empleando los productos antifúngicos se observa el descenso de la proliferación de la flora micótica en el Maíz, mientras que la prueba control (Maíz sin antifúngico) los recuentos fueron aumentando de forma logarítmica semana tras semana. La actuación de estos antifúngicos que contienen ácido propiónico y propianato de amonio es atribuida a la forma no disociada del ácido que penetra en la pared celular e interrumpe el metabolismo de hidratos de carbono y la síntesis de ADN de los mohos. Las ventajas especiales del empleo de compuestos que contengan el acido propiónico y el propianato de amonio es que estos son un complejo amortiguado menos corrosivo que los ácidos puros, adicionalmente, no se genera vapores nocivos e incluso se evitan las quemaduras de las personas que lo manejan, previniendo eficazmente el desarrollo de mohos y sus correspondientes micotoxinas en los granos almacenados. Este tipo de control debe ser aplicado en el Maíz antes de que proliferen los mohos junto con otros métodos como el control de la humedad, la temperatura y las plagas, puesto que si se desatiende alguna de estas variables perderán poder de eficacia los antifúngicos. El acido propiónico es un aditivo usado en diversos alimentos de consumo humano y animal pero el propianato de amonio considerado también como aditivo solo es permitido para usarlo en la prevención de mohos en cereales o materias primas que serán destinadas al procesamiento de piensos para animales según el CODEX ALIMENTARIUS. (3) |
RECOMENDACIONES
El FUNGITEK ACTION se administra específicamente cuando se presente una contaminación alta de mohos en el Maíz, debido a que este antifúngico contiene una mezcla de ácidos donde sus componentes activos y su bajo pH actúan con mayor rapidez sobre el moho con una acción fulminante impidiendo así su proliferación subsiguiente.
Para almacenamientos prolongados del Maíz con una humedad alrededor del 15,5% se recomienda el uso del FUNGITEK GRAIN ó el FUNGITEK DRY con una segunda aplicación trascurridos tres meses.
Una vez aplicados los antifúngicos, los cereales no deben someterse a volteos constantes, puesto que las esporas de los mohos de diseminan rápidamente sobre toda la superficie del maíz generando un crecimiento mas acelerado de los mohos y por consiguiente generándose las micotoxinas.
Para dar continuidad a este proyecto se sugiere realizar un estudio de micotoxinas especialmente de Aflatoxinas y Ocratoxinas, ya que los mohos predominantes y resistentes encontrados en el Maíz tratado con los antifungicos fueron Aspergillus spp. y Penicillium spp.
BIBLIOGRAFIA
Datos de los autores:
GOMEZ, D. Gladys J. Microbióloga UDES, RODRIGUEZ, Rafael., Micólogo UDES, RINCÓN, G. Alix Estudiante Tesista UDES ZOOTEK, C. A. Barquisimeto Estado Lara Venezuela Bacteriología y Laboratorio Clínico UDES, Facultad de Salud, Cúcuta Colombia Investigación Terminada Agosto 2007
Investigación Terminada Agosto 2007

